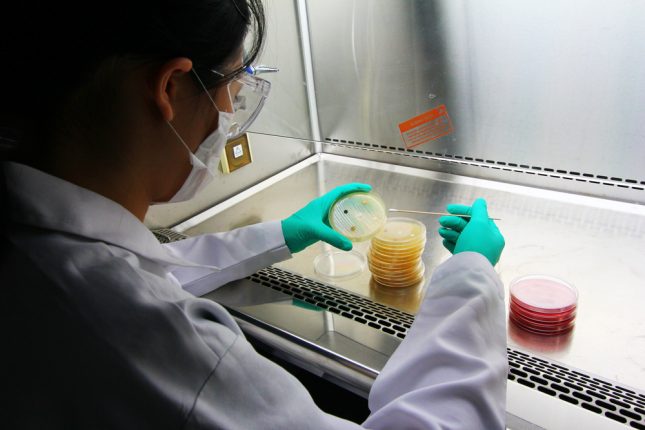

קבוצת חוקרים ספרדים מ-Maimonides Biomedical Research Institute שבקורדובה ערכו מחקר שנועד לבחון את את השינויים במיקרוביוטה של המעיים הקשורים במצב ההורמונלי ובמין הנבדקים. תוצאות המחקר פורסמו בכתב העת Maturitas.
החוקרים כללו במחקר 76 נבדקים: 17 נשים לפני גיל המעבר, 19 גברים בהתאמה לגיל, כקבוצת ביקורת לנשים לפני גיל המעבר, 20 נשים לאחר גיל המעבר ו-20 גברים בהתאמה לגיל כקבוצת ביקורת עבור הנשים לאחר גיל המעבר. כל ארבע הקבוצות הותאמו גם על בסיס מדד מסת הגוף (BMI) ועל בסיס הרקע התזונתי.
החוקרים ניתחו את ההבדלים במיקרוביוטה של המעיים, באנדוטוקסמיה, באינקרטינים במעיים, בציטוקינים פרו-דלקתיים וברמות פלזמה של הורמונים בין נשים לפני ואחרי גיל המעבר, והשוו אותן עם קבוצות הביקורת של הגברים.
נמצא יחס גבוה יותר של פמילקוטס / בקטריאופטס, שכיחות גבוהה יחסית של Lachnospira ורוזבוריה, ורמות גבוהות יותר של- GLP-1 אצל נשים לפני גיל המעבר מאשר אצל נשים לאחר גיל המעבר, שהיו להן רמות דומות לגברים.
לעומת זאת, נצפתה שכיחות מופחתת של פרבוטלה, פרבקטוקוידס ובילופילא ג'נרה, ורמות פלזמה של IL-6 ו-MCP-1 בקרב נשים לפני גיל המעבר מאשר אצל נשים לאחר גיל המעבר, שהיו להן רמות דומות לגברים.
כמו כן, נמצאו רמות גבוהות יותר של GiP ולפטין בנשים מאשר אצל גברים, ללא קשר לגיל המעבר אצל נשים. בנוסף, רמות אדיפונקטין היו גבוהות יותר בקרב נשים לפני גיל המעבר מאשר בקבוצת הביקורת הגברית.
תוצאות המחקר מראות כי ההבדלים בהרכב של מיקרוביוטה במעיים בין המינים ובין נשים במצבים הורמונליים שונים עשויים להיות קשורים בדימורפיזם המיני שנצפה בהיארעות גבוהה במחלות מטבוליות.
מקור: